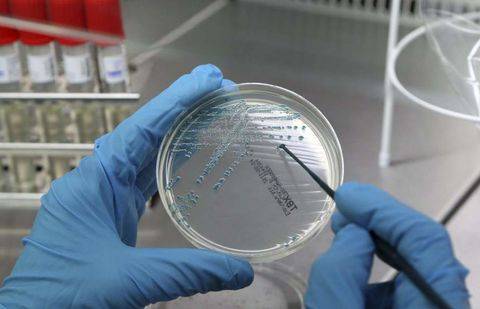

По информации Фонда по защите прав потребителей странами-производителями значатся Кыргызстан, Украина, Латвия и Российская Федерация. Основные несоответствия - нарушение правил маркировки, неправильное указание жира и плотности продукции, а также обнаружение в некоторых продуктах питания бактирий группы кишечной палочки.
"В двух продуктах обнаружены бактерии группы кишечной палочки (Плавленный сырный продукт "Гауда", Россия и Масло крестьянское сливочное 72,5%, Кыргызстан). Причем шесть производителей уже находятся в реестре – с другой продукцией, либо с этим же товаром (нарушения не всегда одни и те же). Реализация несоответствующей молочной продукции выявлена в 4 областях и двух городах Казахстана (Акмолинская, Карагандинская, Алматинская, Кызылординская, Западно-Казахстанская области, Астана и Атырау)", - говорится в сообщении Фонда.
Кроме того, нарушения были выявлены и в мясной продукции. Здесь также несоответствие в маркировке и наличии микроорганизмов в мясе.
"Несоответствующая продукция распространяется в Акмолинской, Атырауской, Кызылординской, Актюбинской и Карагандинской областях. Пять товаропроизводителей с другой продукцией уже находятся в реестре. У ЗАО "Орелпродукт", РФ, Орловская область в таблице уже 12 наименований, по итогам последнего мониторинга не соответствуют еще 2 наименования", - уточняется в пресс-релизе.
В 25-ти наименованиях рыбной продукции, реализуемой в Акмолинской, Павлодарской, Кызылординской и Западно-Казахстанской областях, основной процент несоответствия приходится на маркировку (отсутствие государственного языка РК), в некоторых товарах превышено содержание дрожжей и плесени, выявлено несоответствие помассовой доли сухих веществ. Однако, кто именно является производителем этих продуктов, в Фонде не сообщают. С полным перечнем несоответствующей продукции можно ознакомиться здесь.
-
1🤖📚 ИИ приходит в школы: что изменится в образовании Казахстана с 2026 года
-
3747
-
2
-
34
-
-
2💬 "YouTube вообще не грузит". В Казахтелекоме ответили на жалобы казахстанцев на медленный интернет
-
3692
-
32
-
79
-
-
3💬 Оппозиция Венесуэлы заявила о готовности взять власть после задержания Мадуро
-
3273
-
21
-
80
-
-
4😱 7-летний ребёнок получил серьёзные травмы, скатившись с горки в Павлодаре
-
3434
-
3
-
31
-
-
5❌🇬🇪 Туристов, не имеющих страховку, не впустят в Грузию
-
3390
-
1
-
35
-
-
6❄️ Прогноз погоды на 4 января: снег и метели ожидаются на севере Казахстана
-
3023
-
0
-
2
-
-
7✅ Поиски пропавших подростков завершились в Астане
-
3002
-
0
-
24
-
-
8🔥🎄 Поджёг ёлку в подъезде: жителя Темиртау арестовали на 10 суток
-
2976
-
3
-
46
-
-
9⚠️ Доброе утро! Как проходят ваши выходные? Ловите обзор главных новостей за 2 января
-
3069
-
0
-
11
-
-
10❄️ Прогноз погоды на 3 января: снег и гололёд ожидаются на севере и местами на западе страны
-
3222
-
0
-
8
-
lw-3094948329-4
 USD:
510.1 / 515.1
USD:
510.1 / 515.1
 EUR:
595.5 / 602.5
EUR:
595.5 / 602.5
 RUB:
6.13 / 6.33
RUB:
6.13 / 6.33

